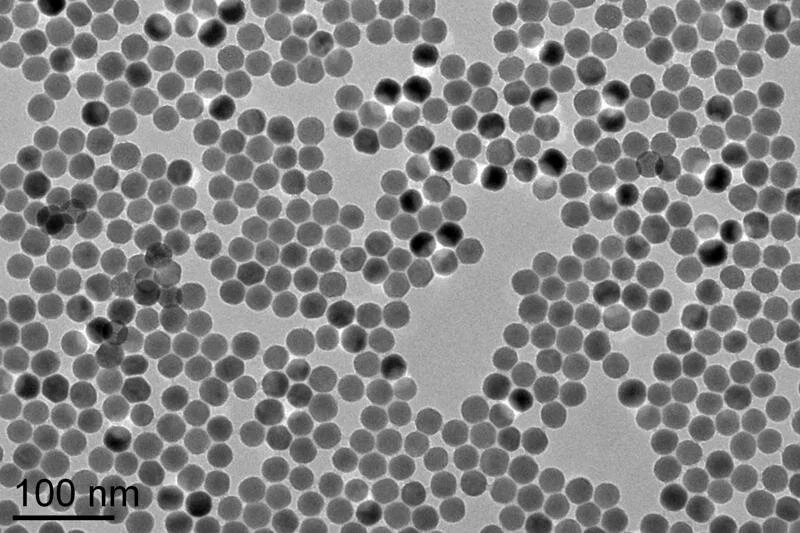

Products
Commercial Implementations of Intelligent Material®
Intelligent Material Solutions, Inc., through its exclusive manufacturing and distribution partner Nova-Vera Inc., provides commercially available products that integrate Intelligent Material® technology directly into inks, coatings, polymers, films, fibers, and painted surfaces. These products enable authentication, traceability, and secure identification to be incorporated seamlessly into existing manufacturing workflows without affecting performance or appearance. Each product format is engineered for compatibility with standard industrial processes and is available for evaluation, pilot integration, and commercial supply.
Intelligent Ink®
Intelligent Ink® is a functional ink formulation designed to incorporate authentication and traceability directly into printed materials, packaging, labels, and coated surfaces. It is compatible with conventional printing methods, including flexographic, gravure, screen, inkjet, and offset printing, allowing straightforward integration into existing production workflows.
Applications include secure printing, product authentication, brand protection, and packaging traceability.
Intelligent Plastic®
Intelligent Plastic® consists of polymer materials engineered to incorporate authentication directly into molded, extruded, and fabricated plastic components. These materials are compatible with standard polymer manufacturing methods, including injection molding and extrusion.
Applications include authentication of plastic components, secure packaging, industrial parts identification, and product traceability.
Intelligent Film®
Intelligent Film® is an engineered film designed to integrate authentication capabilities into packaging, labels, and laminated structures. It can be incorporated into flexible and rigid packaging systems and is compatible with standard lamination and converting processes.
Applications include secure packaging, authentication labels, tamper indication, and protective overlays.
Intelligent Paint®
Intelligent Paint® is a functional coating engineered to incorporate authentication capabilities directly into painted surfaces using standard paint and coating systems. It can be integrated into industrial, commercial, and protective coatings without altering application methods or appearance.
Applications include asset protection, infrastructure marking, equipment authentication, and industrial coatings.
Intelligent Fiber®
Intelligent Fiber® is a functional fiber designed for integration into textiles, composites, and specialty materials. It enables authentication and identification capabilities to be embedded directly at the material level while remaining compatible with conventional textile and composite manufacturing processes.
Applications include textile authentication, brand protection, secure fabrics, and composite material identification.
